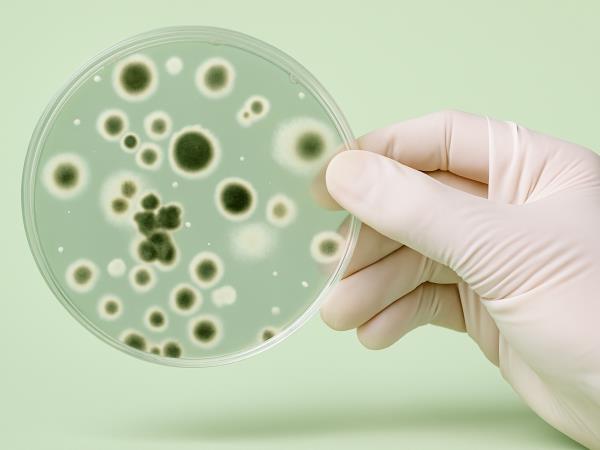
10 znakov, da imate preveč glivic Candide

Dobro je vedeti
10 najbolj presenetljivih superživil
Superživila so tista, ki nam dajo veliko energije in ne zamaščujejo in obremenjujejo telesa
VEČ >



Superživila so tista, ki nam dajo veliko energije in ne zamaščujejo in obremenjujejo telesa
Candida je glivica s katero moramo živeti vse življenje. Ima podobno obliko kot kvas in živi v naših ustih in črevesju














































